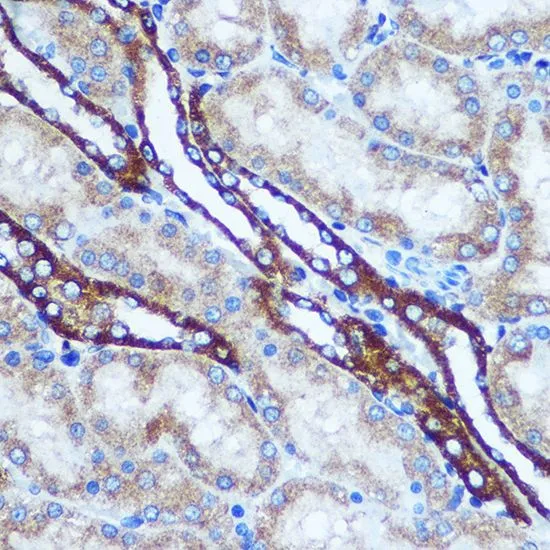

IHC-P analysis of human breast cancer tissue using GTX55652 GSTT1 antibody. Dilution : 1:100
GSTT1 antibody
GTX55652
ApplicationsImmunoFluorescence, Western Blot, ImmunoCytoChemistry, ImmunoHistoChemistry, ImmunoHistoChemistry Paraffin
Product group Antibodies
ReactivityHuman, Mouse, Rat
TargetGSTT1
Overview
- SupplierGeneTex
- Product NameGSTT1 antibody
- Delivery Days Customer9
- Application Supplier NoteWB: 1:500 - 1:2000. ICC/IF: 1:50 - 1:200. IHC-P: 1:50 - 1:200. *Optimal dilutions/concentrations should be determined by the researcher.Not tested in other applications.
- ApplicationsImmunoFluorescence, Western Blot, ImmunoCytoChemistry, ImmunoHistoChemistry, ImmunoHistoChemistry Paraffin
- CertificationResearch Use Only
- ClonalityPolyclonal
- ConjugateUnconjugated
- Gene ID2952
- Target nameGSTT1
- Target descriptionglutathione S-transferase theta 1
- Target synonymsglutathione S-transferase theta-1, GST class-theta-1, glutathione transferase T1-1
- HostRabbit
- IsotypeIgG
- Protein IDP30711
- Protein NameGlutathione S-transferase theta-1
- Scientific DescriptionThe protein encoded by this gene, glutathione S-transferase (GST) theta 1 (GSTT1), is a member of a superfamily of proteins that catalyze the conjugation of reduced glutathione to a variety of electrophilic and hydrophobic compounds. Human GSTs can be divided into five main classes: alpha, mu, pi, theta, and zeta. The theta class includes GSTT1, GSTT2, and GSTT2B. GSTT1 and GSTT2/GSTT2B share 55% amino acid sequence identity and may play a role in human carcinogenesis. The GSTT1 gene is haplotype-specific and is absent from 38% of the population. Alternative splicing of this gene results in multiple transcript variants. [provided by RefSeq, Sep 2015]
- ReactivityHuman, Mouse, Rat
- Storage Instruction-20°C or -80°C,2°C to 8°C
- UNSPSC12352203